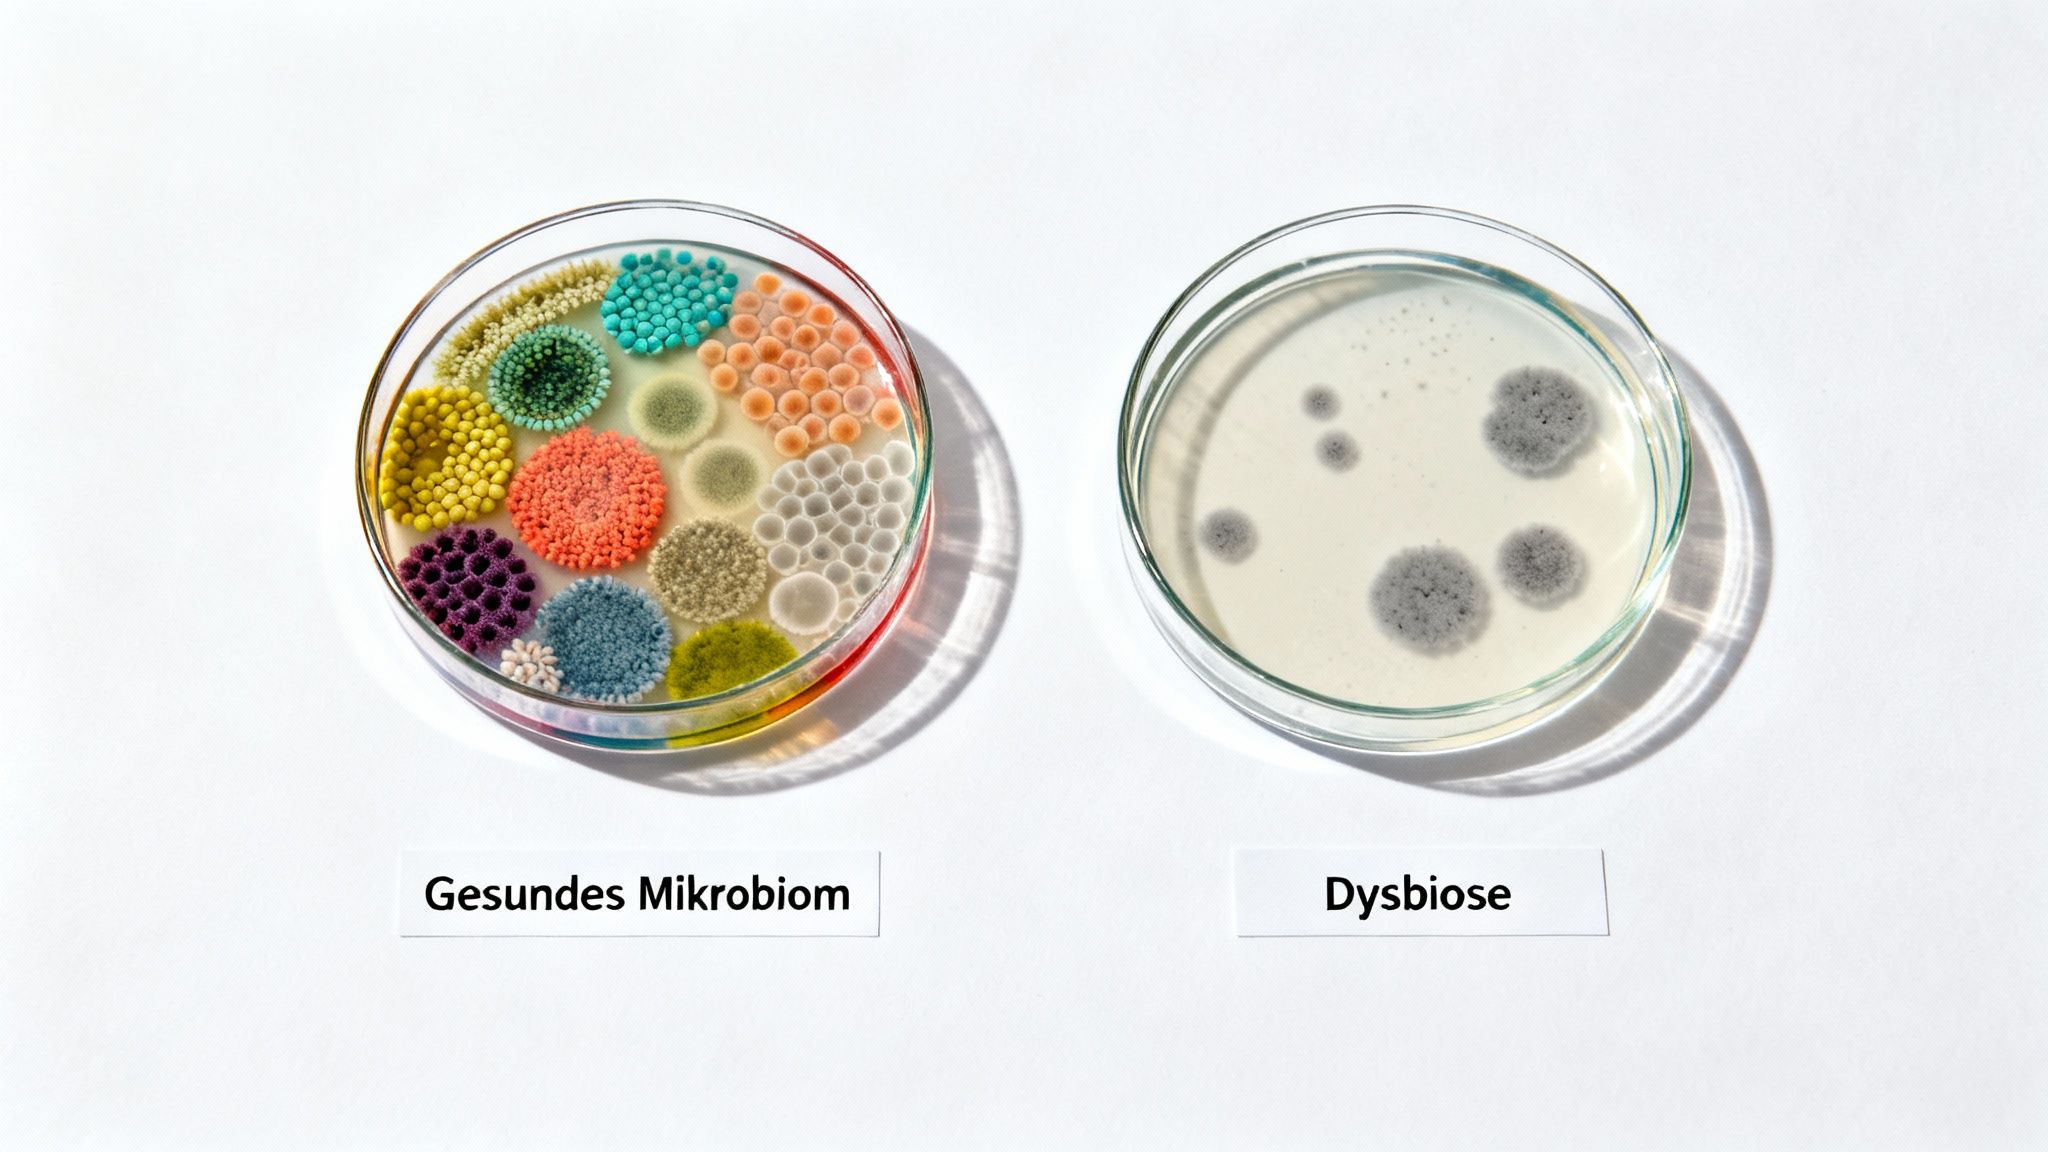
Zwei Petrischalen zeigen ein gesundes Mikrobiom mit vielfältigen Kolonien und eine Dysbiose mit wenigen, grauen Kulturen.

Leaky Gut Syndrom: Dein Test für Klarheit bei Darmbeschwerden
Fühlst du dich oft müde, aufgebläht oder kämpfst mit diffusen Beschwerden, für die sich einfach keine Erklärung finden lässt? Dahinter könnte ein Leaky Gut Syndrom stecken – eine erhöhte Durchlässigkeit deiner Darmwand. Ein gezielter Leaky Gut Syndrom Test kann dir endlich Klarheit verschaffen, ob deine Darmbarriere geschwächt ist und unerwünschte Stoffe in deinen Blutkreislauf gelangen.
Was ein Leaky Gut Syndrom wirklich bedeutet
Stell dir deine Darmwand wie einen hochintelligenten und ziemlich strengen Türsteher vor. Seine Aufgabe ist es, nur erwünschte Gäste – also lebenswichtige Nährstoffe wie Vitamine und Mineralien – in den exklusiven Club deines Blutkreislaufs zu lassen.
Alle ungebetenen Besucher, wie Giftstoffe, Krankheitserreger oder unvollständig verdaute Nahrungsreste, werden konsequent abgewiesen. Dieser Schutzmechanismus ist das stille Fundament deiner gesamten Gesundheit.
Bei einem Leaky Gut Syndrom wird dieser Türsteher jedoch nachlässig. Die winzigen, aber extrem wichtigen Verbindungen zwischen den Zellen deiner Darmwand, die sogenannten Tight Junctions, lockern sich. Plötzlich ist die Barriere nicht mehr dicht, sondern durchlässig – eben „löchrig“ oder „leaky“.
Wenn die Darmbarriere löchrig wird
Diese geschwächte Barriere hat weitreichende Folgen. Partikel, die niemals in deinen Blutkreislauf gelangen sollten, überwinden nun die Darmwand. Dein Immunsystem, das zu etwa 70 % im Darm sitzt, erkennt diese Eindringlinge sofort als Bedrohung und schlägt Alarm. Es startet eine Abwehrreaktion, die zu stillen Entzündungen im gesamten Körper führen kann.
Diese permanenten Entzündungsherde sind oft die wahre Ursache für eine ganze Reihe von Symptomen, die auf den ersten Blick gar nichts mit dem Darm zu tun zu haben scheinen.
Bevor wir weitermachen, hier eine Übersicht typischer Anzeichen, die mit einem Leaky Gut in Verbindung gebracht werden. Vielleicht erkennst du dich in einigen Punkten wieder?
| Symptom-Kategorie | Konkrete Beispiele | Zusammenhang mit Leaky Gut |
|---|---|---|
| Verdauungsprobleme | Chronische Blähungen, Bauchschmerzen, Durchfall, Verstopfung, Reizdarm | Die direkteste Folge einer gestörten Darmfunktion und veränderter Darmflora. |
| Hautprobleme | Akne, Ekzeme, Rosacea, Psoriasis, Hautausschläge | Entzündungsstoffe aus dem Darm gelangen ins Blut und können Hautreaktionen auslösen. |
| Müdigkeit & Erschöpfung | Chronische Müdigkeit, "Brain Fog", Konzentrationsprobleme | Der Körper verbraucht viel Energie für die ständige Entzündungsbekämpfung. |
| Nahrungsmittelunverträglichkeiten | Plötzliche Reaktionen auf Lebensmittel, die früher vertragen wurden | Unverdaute Nahrungsbestandteile gelangen ins Blut und provozieren eine Immunantwort. |
| Stimmungsschwankungen | Angstzustände, Depressionen, Reizbarkeit | Die Darm-Hirn-Achse leitet Entzündungssignale weiter, was die mentale Gesundheit beeinflusst. |
| Gelenkschmerzen | Unspezifische Gelenkschmerzen, Muskelbeschwerden, Arthritis | Systemische Entzündungen, die durch die Immunreaktion im Darm getriggert werden. |
| Autoimmunerkrankungen | Hashimoto-Thyreoiditis, Zöliakie, Rheumatoide Arthritis | Eine durchlässige Darmwand wird als ein zentraler Auslöser für Autoimmunreaktionen diskutiert. |
Diese Tabelle zeigt, wie weitreichend die Folgen sein können. Ein Leaky Gut ist eben kein isoliertes Darmproblem, sondern ein Zustand, der deine gesamte Gesundheit aus dem Gleichgewicht bringen kann.
Die Wiederherstellung einer intakten Darmbarriere ist daher ein entscheidender Schritt zu mehr Wohlbefinden und Vitalität.
Die Verbindung zum Reizdarmsyndrom
Die Symptome eines Leaky Gut Syndroms überschneiden sich stark mit denen des Reizdarmsyndroms (RDS), und das ist kein Zufall. Schätzungsweise 11 Millionen Menschen in Deutschland leiden an RDS, und bei etwa 70 Prozent dieser Patienten wurde eine gestörte Darmbarriere nachgewiesen.
Führende Gastroenterologen betonen immer wieder, wie Faktoren wie chronischer Stress, eine unausgewogene Ernährung oder die Einnahme von Antibiotika die Tight Junctions schwächen können. Das ebnet den Weg für Bakterien und Toxine in den Blutkreislauf. Wenn du mehr über diese Zusammenhänge lesen möchtest, findest du hier spannende Einblicke zum Thema Darmgesundheit bei Presseportal.de.
Ein Leaky Gut Syndrom Test ist also nicht nur eine Möglichkeit, Vermutungen zu bestätigen. Er ist ein wichtiges Werkzeug, um der Ursache deiner Beschwerden auf den Grund zu gehen und endlich gezielt handeln zu können.
Wenn du jetzt schon tiefer in die Materie einsteigen möchtest, lies auch unseren umfassenden Artikel über das Leaky Gut Syndrom und seine Mechanismen.
Die aussagekräftigsten Tests bei Leaky Gut
Du hast das Gefühl, dass ein Leaky Gut hinter deinen Beschwerden stecken könnte? Dann ist der nächste logische Schritt, für Klarheit zu sorgen. Statt weiter im Dunkeln zu tappen und dich auf Vermutungen zu verlassen, kannst du heute auf wissenschaftlich fundierte Methoden zurückgreifen, um die Gesundheit deiner Darmbarriere ganz gezielt zu überprüfen.
Ein Test auf das Leaky Gut Syndrom muss dabei gar nicht kompliziert sein. Moderne Analyseverfahren sind darauf ausgelegt, dir präzise Einblicke zu geben, wie gut dein Darm funktioniert. Es geht nicht nur um ein einfaches „Ja“ oder „Nein“, sondern darum, zu verstehen, wo genau das Problem liegen könnte.
Diese Infografik zeigt sehr anschaulich, wie sich aus einem gesunden Darm schrittweise ein Leaky Gut entwickelt und welche Symptome daraus im ganzen Körper resultieren können.

Man erkennt gut, wie eine gestörte Darmbarriere eine ganze Kaskade von Reaktionen im Organismus anstoßen kann.
Der Zonulin-Test als Goldstandard
Der wohl bekannteste und wichtigste Test, wenn es um Leaky Gut geht, ist die Messung von Zonulin. Du kannst dir Zonulin wie eine Art „Schlüsselmeister“ für deine Darmwand vorstellen. Dieses Protein steuert nämlich, wie durchlässig die sogenannten Tight Junctions sind – also die winzigen Schleusen zwischen deinen Darmzellen.
Ist der Zonulin-Wert im Stuhl oder Blut erhöht, ist das ein starkes Indiz dafür, dass diese „Türen“ zu oft und zu lange offenstehen. Damit ist der Wert ein direkter Marker für eine erhöhte Durchlässigkeit des Darms (intestinale Permeabilität).
Der Lactulose-Mannitol-Test: Ein echter Funktionstest
Eine weitere, sehr aussagekräftige Methode ist der Lactulose-Mannitol-Test. Dieser Test prüft nicht nur einen einzelnen Wert, sondern die tatsächliche Funktion deiner Darmbarriere. Dafür trinkst du eine spezielle Lösung, die zwei unterschiedliche Zuckermoleküle enthält: Mannitol (ein kleines Molekül) und Lactulose (ein großes Molekül).
- Mannitol: Das kleine Molekül sollte eine gesunde Darmwand mühelos passieren und im Blutkreislauf ankommen.
- Lactulose: Das deutlich größere Molekül sollte hingegen kaum durchkommen.
Anschließend wird im Urin gemessen, wie viel von beiden Zuckerarten ausgeschieden wird. Findet man dort plötzlich eine hohe Menge an Lactulose, ist das ein klares Zeichen dafür, dass die Darmbarriere löchrig ist und eben auch größere Moleküle durchlässt, die dort nicht hingehören.
Weitere wichtige Marker, die das Bild vervollständigen
Neben den Tests, die direkt die Durchlässigkeit messen, gibt es noch andere wichtige Marker. Sie liefern oft die entscheidenden Puzzleteile, um ein vollständiges Bild deiner Darmgesundheit zu erhalten und den Verdacht auf ein Leaky Gut Syndrom zu untermauern.
Ein einzelner Wert erzählt selten die ganze Geschichte. Erst die Kombination verschiedener Marker liefert ein klares Bild und hilft dabei, wirklich gezielte Maßnahmen zu ergreifen.
Zu diesen ergänzenden Indikatoren zählen unter anderem:
- Alpha-1-Antitrypsin: Dieses Protein wird eigentlich in der Leber gebildet. Findet man es in größeren Mengen im Stuhl, deutet das stark auf eine durchlässige Darmschleimhaut und oft auch auf entzündliche Prozesse hin.
- Calprotectin: Ein etablierter Entzündungsmarker im Stuhl. Erhöhte Werte signalisieren eine aktive Entzündung im Darm, die sehr häufig mit einer gestörten Barrierefunktion Hand in Hand geht.
- LPS-Antikörper: Lipopolysaccharide (LPS) sind Bestandteile der äußeren Zellwand von bestimmten Darmbakterien. Wenn sie durch eine löchrige Darmwand ins Blut gelangen, reagiert das Immunsystem und bildet Antikörper dagegen. Der Nachweis dieser Antikörper ist ein klares Signal, dass die Darmbarriere ihre Schutzfunktion nicht mehr richtig erfüllt.
Jeder dieser Tests liefert also wertvolle, aber unterschiedliche Informationen. Während Zonulin die Steuerung der „Türen“ misst, zeigt der Lactulose-Mannitol-Test, was tatsächlich durchkommt. Entzündungsmarker und LPS-Antikörper decken schließlich die Folgen einer gestörten Barriere auf.
Welcher Test für dich der richtige ist, hängt von deinen individuellen Symptomen und deiner Situation ab. Um noch tiefer in die verschiedenen Optionen einzutauchen, findest du in unserem Ratgeber über Leaky Gut Tests weitere detaillierte Informationen, die dir bei der Entscheidung helfen.
Was der Zonulin-Test über deine Darmgesundheit verrät
Wenn wir über das Leaky Gut Syndrom sprechen, taucht fast immer ein Name auf: Zonulin. Man kann sich dieses Protein am besten als den Türsteher der Darmbarriere vorstellen. Es ist der einzige körpereigene Regulator, von dem wir bisher wissen, dass er die Aufgabe hat, die engen Verbindungen zwischen den Darmzellen – die sogenannten Tight Junctions – gezielt und nur kurzzeitig zu öffnen.
Dieser Mechanismus ist im Grunde genial und absolut lebenswichtig. Er erlaubt dem Körper, ganz kontrolliert Flüssigkeit, Nährstoffe und sogar Immunzellen zwischen dem Darm und dem Blutkreislauf auszutauschen. Ein Problem wird das Ganze erst, wenn dieser Türsteher quasi dauerhaft das Signal gibt, die Türen offen zu lassen.

Ein permanent erhöhter Zonulin-Spiegel ist deshalb ein ziemlich klares Alarmsignal. Er deutet darauf hin, dass die Darmbarriere ihre wichtige Filterfunktion nicht mehr richtig erfüllt und potenziell schädliche Substanzen in den Körper gelangen können.
Was lässt den Zonulin-Spiegel ansteigen?
Die Freisetzung von Zonulin passiert nicht einfach so. Es gibt ganz konkrete Auslöser, die den Körper dazu bringen, die Schleusen zu öffnen. Diese Faktoren zu kennen, ist der erste wichtige Schritt, um die Ursachen hinter Beschwerden zu verstehen und endlich gezielt gegenzusteuern.
Zu den bekanntesten Triggern gehören:
- Gliadin (ein Baustein von Gluten): Studien deuten darauf hin, dass Gliadin bei vielen Menschen – und nicht nur bei Zöliakie-Betroffenen – die Zonulin-Ausschüttung anregen kann. Das erklärt auch, warum eine glutenärmere Ernährung bei Darmproblemen oft eine spürbare Linderung bringt.
- Bestimmte Darmbakterien: Ein Ungleichgewicht in der Darmflora (Dysbiose) kann ebenfalls die Zonulin-Werte in die Höhe treiben. Einige Bakterienstämme produzieren Stoffe, die die Darmzellen direkt zur Freisetzung von Zonulin anregen.
- Chronischer Stress: Dauerhafter Stress, egal ob psychisch oder physisch, funkt über die sogenannte Darm-Hirn-Achse direkt in die Funktion der Darmbarriere hinein. Stresshormone können die Stabilität der Tight Junctions schwächen.
Aber auch andere Einflüsse wie Umweltgifte oder eine Ernährung, die reich an stark verarbeiteten Lebensmitteln und Zucker ist, können dazu beitragen, dieses System chronisch zu aktivieren.
Wie ein Zonulin-Test funktioniert und was er dir sagt
Ein Zonulin-Test ist zum Glück unkompliziert. Er lässt sich sowohl im Blut (Serum) als auch im Stuhl durchführen. Um die Situation direkt vor Ort, also an der Darmschleimhaut, zu beurteilen, hat sich die Messung im Stuhl als besonders aussagekräftig erwiesen.
Ein erhöhter Zonulin-Wert ist mehr als nur ein abstrakter Laborbefund. Er ist ein handfester Hinweis darauf, dass deine Darmbarriere ihren Schutzauftrag vernachlässigt und dein Immunsystem dadurch möglicherweise unter Dauerstress steht.
Die Interpretation der Ergebnisse ist dabei ziemlich eindeutig. Der Laborbericht liefert klare Referenzbereiche, die dir zeigen, ob dein Wert im normalen, leicht erhöhten oder stark erhöhten Bereich liegt.
- Normaler Wert: Alles im grünen Bereich. Deine Darmbarriere scheint stabil und die Tight Junctions funktionieren gut.
- Leicht erhöhter Wert: Das kann auf eine beginnende oder auch nur vorübergehende Störung hindeuten. Oft lässt sich hier mit gezielten Anpassungen bei Ernährung und Lebensstil schon eine Menge bewirken.
- Stark erhöhter Wert: Ein klares Signal für eine deutlich erhöhte Darmdurchlässigkeit. Hier ist es wichtig, den Ursachen auf den Grund zu gehen und eine umfassendere Strategie zu entwickeln, um die Darmschleimhaut zu regenerieren.
Ein Test für das Leaky Gut Syndrom, der Zonulin misst, gibt dir also ein wertvolles Werkzeug an die Hand. Er zeigt nicht nur ein Problem auf, sondern liefert auch den entscheidenden Ansatzpunkt, um deine Darmgesundheit wieder selbst in die Hand zu nehmen. Du verstehst besser, was in deinem Körper abläuft, und kannst dein Ergebnis nutzen, um die nächsten sinnvollen Schritte für dein Wohlbefinden zu planen.
Heimtests oder Laboranalyse beim Arzt
Du möchtest Klarheit über deine Darmgesundheit, bist dir aber unsicher, welcher Weg der richtige für einen Leaky-Gut-Test ist? Die Wahl zwischen einem modernen Heimtest und der klassischen Laboranalyse in der Arztpraxis kann zunächst verwirrend wirken. Beide Wege haben absolut ihre Berechtigung, unterscheiden sich aber in wichtigen Punkten wie Zugänglichkeit, Aufwand und der Art der Betreuung.
Moderne Heimtests, wie mybody® sie anbietet, sind eine super Möglichkeit, um einen ersten wissenschaftlich fundierten Einblick zu bekommen – und das alles ganz entspannt von zu Hause aus. Du nimmst eine kleine Probe, schickst sie an ein zertifiziertes Fachlabor und bekommst am Ende einen detaillierten, aber vor allem verständlichen Ergebnisbericht mit persönlichen Empfehlungen.
Der Heimtest als unkomplizierter erster Schritt
Der größte Pluspunkt eines Heimtests? Ganz klar die einfache Handhabung und die übersichtliche Aufbereitung der Daten. Anstatt wochenlang auf einen Facharzttermin zu warten, kannst du selbst aktiv werden und den ersten Schritt machen. Das gibt dir die Kontrolle über deine Gesundheit zurück und liefert dir schnell wichtige Anhaltspunkte, ohne dass du dafür das Haus verlassen musst.
Ein weiterer entscheidender Vorteil ist die Verständlichkeit. Die Berichte sind meist so gestaltet, dass du auch als Laie sofort verstehst, was die Werte bedeuten und welche nächsten Schritte sinnvoll sein könnten. Das schärft das Bewusstsein für den eigenen Körper und befähigt dich, gut informierte Entscheidungen zu treffen.
Die Möglichkeit, einen Test für das Leaky Gut Syndrom diskret und einfach von zu Hause aus durchzuführen, senkt die Hemmschwelle und macht Diagnostik für jeden zugänglich, der Verantwortung für seine Gesundheit übernehmen möchte.
Die ärztliche Laboranalyse für den Gesamtüberblick
Eine Laboranalyse beim Arzt ist dagegen meist Teil einer größeren diagnostischen Abklärung. Hier werden die Ergebnisse direkt von einem Mediziner in den Kontext deiner gesamten Krankengeschichte und möglicher Vorerkrankungen eingeordnet. Dieser Weg ist vor allem dann der richtige, wenn du bereits unter starken oder sehr komplexen Symptomen leidest und eine umfassende medizinische Betreuung brauchst.
Der Arzt kann basierend auf den Laborwerten direkt weitere Untersuchungen veranlassen oder eine gezielte Therapie einleiten. Der Nachteil kann allerdings der höhere Zeitaufwand sein, der mit Terminvereinbarungen, Wartezeiten und oft mehreren Praxisbesuchen verbunden ist.
Um dir die Entscheidung zu erleichtern, haben wir die beiden Ansätze direkt gegenübergestellt.
Heimtests im Vergleich zur ärztlichen Laboranalyse
Ein direkter Vergleich der wichtigsten Kriterien, um dir bei der Entscheidung für den passenden Testansatz zu helfen.
| Merkmal | mybody® Heimtest | Ärztliche Laboranalyse |
|---|---|---|
| Durchführung | Bequem und diskret von zu Hause | In der Arztpraxis oder einem Labor |
| Aufwand | Gering, keine Wartezeiten für Termine | Höher, erfordert Terminvereinbarungen |
| Ergebnisbericht | Leicht verständlich, mit konkreten Handlungsempfehlungen | Fachlicher Laborbefund, Interpretation durch den Arzt |
| Geschwindigkeit | Ergebnisse oft innerhalb weniger Tage verfügbar | Kann je nach Praxis und Labor länger dauern |
| Kosten | Meist transparente und fixe Kosten (Selbstzahler) | Abhängig von Krankenkasse und Untersuchungs-umfang |
| Beratung | Personalisierte Empfehlungen, oft optionaler Experten-Support | Direkte ärztliche Beratung und Einordnung in die Anamnese |
Am Ende hängt die Wahl ganz von deiner persönlichen Situation ab. Für einen fundierten ersten Einblick und konkrete, umsetzbare Tipps ist ein Heimtest eine hervorragende, unkomplizierte Option. Möchtest du mehr darüber erfahren, wie ein Stuhltest für Zuhause genau funktioniert und welche Vorteile er bietet, findest du alle wichtigen Informationen in unserem ausführlichen Ratgeber.
Klar ist aber auch: Bei schweren oder unklaren Symptomen bleibt der Gang zum Arzt unerlässlich, um die Ursachen umfassend abzuklären.
Dein Testergebnis richtig interpretieren und handeln
Der Moment ist da: Du hältst deinen Befund in den Händen. Vielleicht zeigt der Test für das Leaky Gut Syndrom einen erhöhten Zonulin-Wert oder andere Auffälligkeiten. Das mag sich im ersten Moment vielleicht beunruhigend anfühlen, ist aber in Wahrheit ein entscheidender Wendepunkt. Sieh es nicht als Ende, sondern als den Anfang deines ganz persönlichen Weges zu mehr Wohlbefinden.
Dieses Ergebnis ist kein Urteil, sondern ein wertvolles Werkzeug. Es ist wie eine persönliche Landkarte, die dir endlich zeigt, wo genau du ansetzen kannst, um deine Darmgesundheit gezielt zu stärken. Jetzt kannst du aufhören zu raten und anfangen, gezielt zu handeln.
Ein positives Testergebnis bedeutet schlicht, dass du nun die Chance hast, deinen Körper aktiv bei der Regeneration zu unterstützen. Du tappst nicht mehr im Dunkeln, sondern hast einen konkreten Ansatzpunkt für positive Veränderungen.
Die ersten Schritte nach dem Befund
Ein erhöhter Wert, zum Beispiel bei Zonulin, bestätigt, dass deine Darmbarriere durchlässiger ist, als sie sein sollte. Die gute Nachricht ist: Die Zellen der Darmschleimhaut erneuern sich bemerkenswert schnell. Mit den richtigen Maßnahmen kannst du diesen Prozess aktiv fördern und die Stabilität deiner Darmwand wiederherstellen.
Der Fokus liegt dabei auf zwei zentralen Säulen, die Hand in Hand gehen: Ernährung und Lebensstil.
Dein Testergebnis ist der Startschuss. Ab jetzt geht es nicht mehr darum, ein Problem zu finden, sondern darum, Lösungen zu schaffen. Jeder kleine Schritt in die richtige Richtung unterstützt deinen Darm bei seiner Regeneration.
Diese beiden Bereiche bieten dir die wirkungsvollsten Hebel, um deine Darmgesundheit von Grund auf zu verbessern. Es geht dabei nicht um Perfektion von heute auf morgen, sondern um konsequente, positive Veränderungen im Alltag.
Ernährung als Schlüssel zur Regeneration
Deine Ernährung ist wohl das mächtigste Werkzeug, um die Darmbarriere zu heilen. Der Grundgedanke ist ganz einfach: Gib deinem Darm die Bausteine, die er zur Reparatur braucht, und nimm ihm gleichzeitig die Dinge weg, die ihn zusätzlich reizen.
- Entzündungsfördernde Lebensmittel reduzieren: Stark verarbeitete Produkte, Zucker, übermäßig viel Gluten und minderwertige Fette können die Darmschleimhaut unnötig belasten. Versuche, diese ganz bewusst zu meiden.
- Heilende Nährstoffe integrieren: Bestimmte Nährstoffe sind wahre Superhelden für deine Darmzellen. Dazu gehört die Aminosäure L-Glutamin, die als Hauptenergiequelle für die Darmzellen dient, sowie Zink und Omega-3-Fettsäuren, die Entzündungen hemmen und die Reparatur der Zellverbindungen unterstützen.
- Prä- und probiotische Lebensmittel einbauen: Fermentiertes wie Kefir oder Sauerkraut liefert nützliche Bakterien (Probiotika). Ballaststoffreiche Lebensmittel wie Lauch, Zwiebeln oder Spargel dienen diesen guten Darmbewohnern als Futter (Präbiotika).
Wenn du hier tiefer einsteigen möchtest, findest du in unserem umfassenden Guide zur Leaky-Gut-Ernährungstherapie viele praktische Tipps und wissenschaftlich fundierte Empfehlungen.
Den Lebensstil darmfreundlich gestalten
Neben der Ernährung spielt dein Lebensstil eine mindestens genauso wichtige Rolle. Chronischer Stress ist einer der größten Feinde einer gesunden Darmbarriere, denn er kann die Ausschüttung von Zonulin direkt beeinflussen und Entzündungen im Körper fördern.
Setze hier gezielt an, um deinem Körper die nötige Ruhe zur Regeneration zu geben:
- Stressmanagement etablieren: Finde eine Methode, die wirklich zu dir passt. Ob Meditation, Yoga, Spaziergänge in der Natur oder einfache Atemübungen – schon 10–15 Minuten täglich können einen riesigen Unterschied machen.
- Schlaf zur Priorität machen: Während du schläfst, laufen im Körper die wichtigsten Reparaturprozesse ab. Sorge für 7–8 Stunden erholsamen Schlaf pro Nacht, am besten in einer dunklen und kühlen Umgebung.
- Bewegung integrieren: Regelmäßige, moderate Bewegung wie zügiges Gehen oder Radfahren fördert die Darmtätigkeit und wirkt entzündungshemmend. Aber übertreibe es nicht – zu intensives Training kann den Körper wiederum stressen.
Manchmal ist es absolut sinnvoll, die Ergebnisse und die nächsten Schritte mit einem Experten zu besprechen. Ein Arzt, Heilpraktiker oder spezialisierter Ernährungsberater kann dir helfen, eine ganzheitliche Strategie zu entwickeln, die perfekt auf deine individuellen Bedürfnisse zugeschnitten ist.
Warum dein Mikrobiom der Schlüssel ist
Ein Test auf das Leaky Gut Syndrom, der zum Beispiel den Zonulin-Wert misst, gibt dir einen wichtigen Hinweis auf den Zustand deiner Darmbarriere. Aber dieser Wert ist oft nur das Symptom einer viel tiefer liegenden Ursache. Um deine Darmgesundheit wirklich an der Wurzel zu packen, müssen wir einen Schritt weiter gehen und uns das komplexe Ökosystem in deinem Darm ansehen: dein Mikrobiom.
Stell dir dein Mikrobiom wie einen bunten, artenreichen Garten vor. In diesem Garten leben Billionen von Mikroorganismen – hauptsächlich Bakterien –, die in einer empfindlichen Balance zusammenarbeiten. Das sind keine passiven Mitbewohner, sondern fleißige Helfer, die entscheidend zu deinem Wohlbefinden beitragen.
Ist die Gemeinschaft deiner Darmbakterien vielfältig und gesund, übernehmen sie lebenswichtige Aufgaben für dich. Sie stärken aktiv deine Darmbarriere, produzieren wichtige Nährstoffe wie Vitamin K und einige B-Vitamine und trainieren sogar dein Immunsystem, damit es richtig auf Bedrohungen reagiert.
Wenn der Garten aus dem Gleichgewicht gerät
Gerät dieses fein abgestimmte System aber aus der Balance, spricht man von einer Dysbiose. Das ist so, als würde in deinem Garten plötzlich Unkraut wuchern und die nützlichen Pflanzen verdrängen. Schädliche Bakterien können sich breitmachen und die Oberhand gewinnen.
Diese unerwünschten Mikroben produzieren oft Stoffwechselprodukte, die deiner Darmschleimhaut direkt schaden. Sie können Substanzen freisetzen, die die „Tight Junctions“ schwächen und so die Zonulin-Produktion ankurbeln – der direkte Weg zu einem Leaky Gut.
Ein Leaky Gut ist also selten ein isoliertes Problem der Darmwand. Vielmehr ist es die logische Folge eines gestörten Mikrobioms. Ein reiner Leaky-Gut-Test zeigt dir, dass die Tür offensteht, aber erst die Mikrobiom-Analyse verrät dir, warum.
Deshalb ist ein einzelner Leaky-Gut-Test oft nur die halbe Wahrheit. Er deckt zwar die erhöhte Durchlässigkeit auf, aber nicht die eigentliche Ursache dahinter. Und genau hier kommt die entscheidende Rolle einer umfassenden Mikrobiom-Analyse ins Spiel.
Das Gesamtbild durch eine Mikrobiom-Analyse verstehen
Eine detaillierte Analyse deines Darm-Mikrobioms, wie sie etwa mybody® anbietet, liefert dir das fehlende Puzzleteil. Sie schaut tiefer als ein einzelner Marker und zeichnet ein vollständiges Bild von der Gesundheit deines „Darmgartens“.
Eine solche Analyse kann dir ganz genau aufzeigen:
- Wie es um deine bakterielle Vielfalt bestellt ist: Eine hohe Vielfalt gilt als Zeichen für ein robustes und gesundes Mikrobiom.
- Ob eine Dysbiose vorliegt: Das Verhältnis von nützlichen zu potenziell schädlichen Bakterien wird sichtbar.
- Welche wichtigen Bakterienstämme dir fehlen: Sie erkennt zum Beispiel, ob es dir an wichtigen Produzenten von Butyrat fehlt – einer kurzkettigen Fettsäure, die als Hauptenergiequelle für deine Darmzellen dient.
Mit diesem Wissen bekommst du endlich eine klare und umsetzbare Anleitung. Du kannst gezielt gegensteuern, indem du deinen guten Darmbewohnern genau das Futter gibst, das sie brauchen. Das gelingt zum Beispiel durch präbiotische Ballaststoffe aus Lebensmitteln wie Chicorée, Artischocken oder Lauch.
Die Analyse deines Mikrobioms ist damit der Schlüssel zu einer langfristigen und ursachenorientierten Strategie für deine Darmgesundheit. Sie erlaubt es dir, nicht nur Symptome zu bekämpfen, sondern das Fundament deines Wohlbefindens von Grund auf zu stärken.
Noch Fragen zum Leaky Gut Test? Hier sind die Antworten
Du hast noch offene Fragen zum Leaky Gut Syndrom Test? Das ist völlig verständlich, denn das Thema ist komplex. Hier haben wir die wichtigsten Punkte für dich zusammengefasst – kurz, knackig und ohne Fachchinesisch.
Wie lange dauert es, bis sich ein Leaky Gut verbessert?
Geduld ist hier der Schlüssel. Die Regenerationszeit deiner Darmschleimhaut ist so individuell wie du selbst und hängt stark davon ab, wie ausgeprägt die Störung ist und wie konsequent du deine Ernährung und deinen Lebensstil anpasst.
Die Zellen deiner Darmwand erneuern sich zwar blitzschnell, oft innerhalb weniger Tage. Die eigentliche Arbeit – nämlich die Wiederherstellung der schützenden Barriere und des gesunden Mikrobioms – ist aber ein Marathon, kein Sprint.
Viele spüren erste positive Veränderungen nach etwa vier bis sechs Wochen, wenn sie ihre Gewohnheiten umstellen. Für eine wirklich tiefgreifende und nachhaltige Heilung solltest du aber eher in Monaten als in Wochen denken.
Kann ein Test auch falsch-negativ sein?
Ja, das ist absolut möglich. Ein einzelner Wert wie das Zonulin ist nur eine Momentaufnahme. Faktoren wie deine Ernährung am Vortag oder dein aktuelles Stresslevel können das Ergebnis beeinflussen. Ein unauffälliger Befund schließt eine gestörte Darmfunktion also nicht zu 100 % aus, vor allem, wenn deine Symptome weiterhin bestehen.
Ein Test liefert wertvolle Daten, aber er sollte immer im Kontext deiner Symptome und deines allgemeinen Wohlbefindens betrachtet werden. Dein Körpergefühl ist und bleibt ein wichtiger Wegweiser auf deinem Gesundheitsweg.
Deshalb ist ein umfassenderer Blick, der vielleicht auch Entzündungsmarker oder eine Mikrobiom-Analyse einbezieht, oft viel aussagekräftiger als ein einzelner Messwert.
Welche Rolle spielt Gluten bei einem Leaky Gut Test?
Gluten, genauer gesagt sein Bestandteil Gliadin, ist einer der bekanntesten Trigger, der die Ausschüttung von Zonulin anregt. Das kann die „Schleusen“ zwischen deinen Darmzellen (die Tight Junctions) kurzzeitig öffnen und so die Darmdurchlässigkeit erhöhen – sogar bei Menschen, die keine Zöliakie haben.
Wenn du also schon wochenlang komplett auf Gluten verzichtest, bevor du einen Test machst, könnte das Ergebnis unauffällig ausfallen, obwohl dein Darm eigentlich sensibel reagiert.
Für ein ehrliches Bild deiner Darmreaktion auf deinen Alltag solltest du dich vor dem Test ganz normal ernähren. Es sei denn natürlich, dein Arzt oder dein Therapeut hat dir ausdrücklich etwas anderes empfohlen.
mybody® ist dein Partner für wissenschaftlich fundierte Gesundheitsanalysen. Wir helfen dir dabei, die Signale deines Körpers besser zu verstehen und gezielte Schritte für mehr Wohlbefinden zu gehen. Entdecke, wie du mit einer detaillierten Analyse deiner Darmgesundheit den Grundstein für neue Vitalität legen kannst.












































































Share:
Darmflora aufbauen: Wie lange dauert es wirklich?
Ständig müde trotz ausreichend schlaf was wirklich dahintersteckt